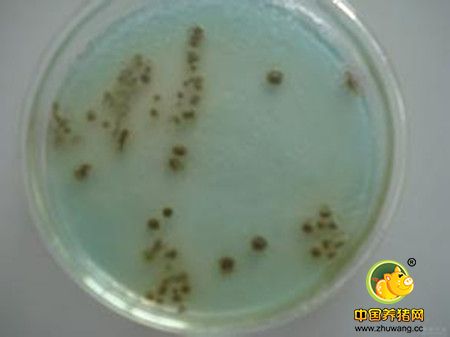

病雏或死雏的新鲜器官可接种营养性琼脂平板或斜面,所有粪样和处于分解状态的样品在选择性肉汤中增菌24~48,以后再接种选择性琼脂。常用选择性增菌肉汤为亚硒酸盐F肉汤和四硫磺酸盐亮绿(BG)肉汤,固定选择性培养基以BG琼脂。选择在琼脂平板上出现的典型菌落接种三糖铁和赖氨酸铁琼脂斜面,对呈典型反应者进行生化反应。
2.生化反应
发酵葡萄糖、麦芽糖、山梨醇并产气;不发酵蔗糖、乳糖;不产生吲哚;甲基红阳性;尿素不水解;氰化钾阴性;硝酸盐被还原。
3.快速检测
检测食品、饲料和临诊沙门氏菌的新方法,用单克隆抗体和核酸探针为基础的检测沙门菌的诊断试剂盒。
4.血清学检测
经分离成纯培养并经生化鉴定的所有沙门菌均应进行血清鉴定。因副伤寒沙门菌的血清型很多,目前检测是针对鼠伤寒沙门菌的。血清学方法有微量凝集试验、快速全血平板试验、常量试管凝集试验等。
血清学方法其缺点是:肠道带菌者可能没有血清学应答,阳性反应者的滴度波动很大,只能检测少数抗原型。


